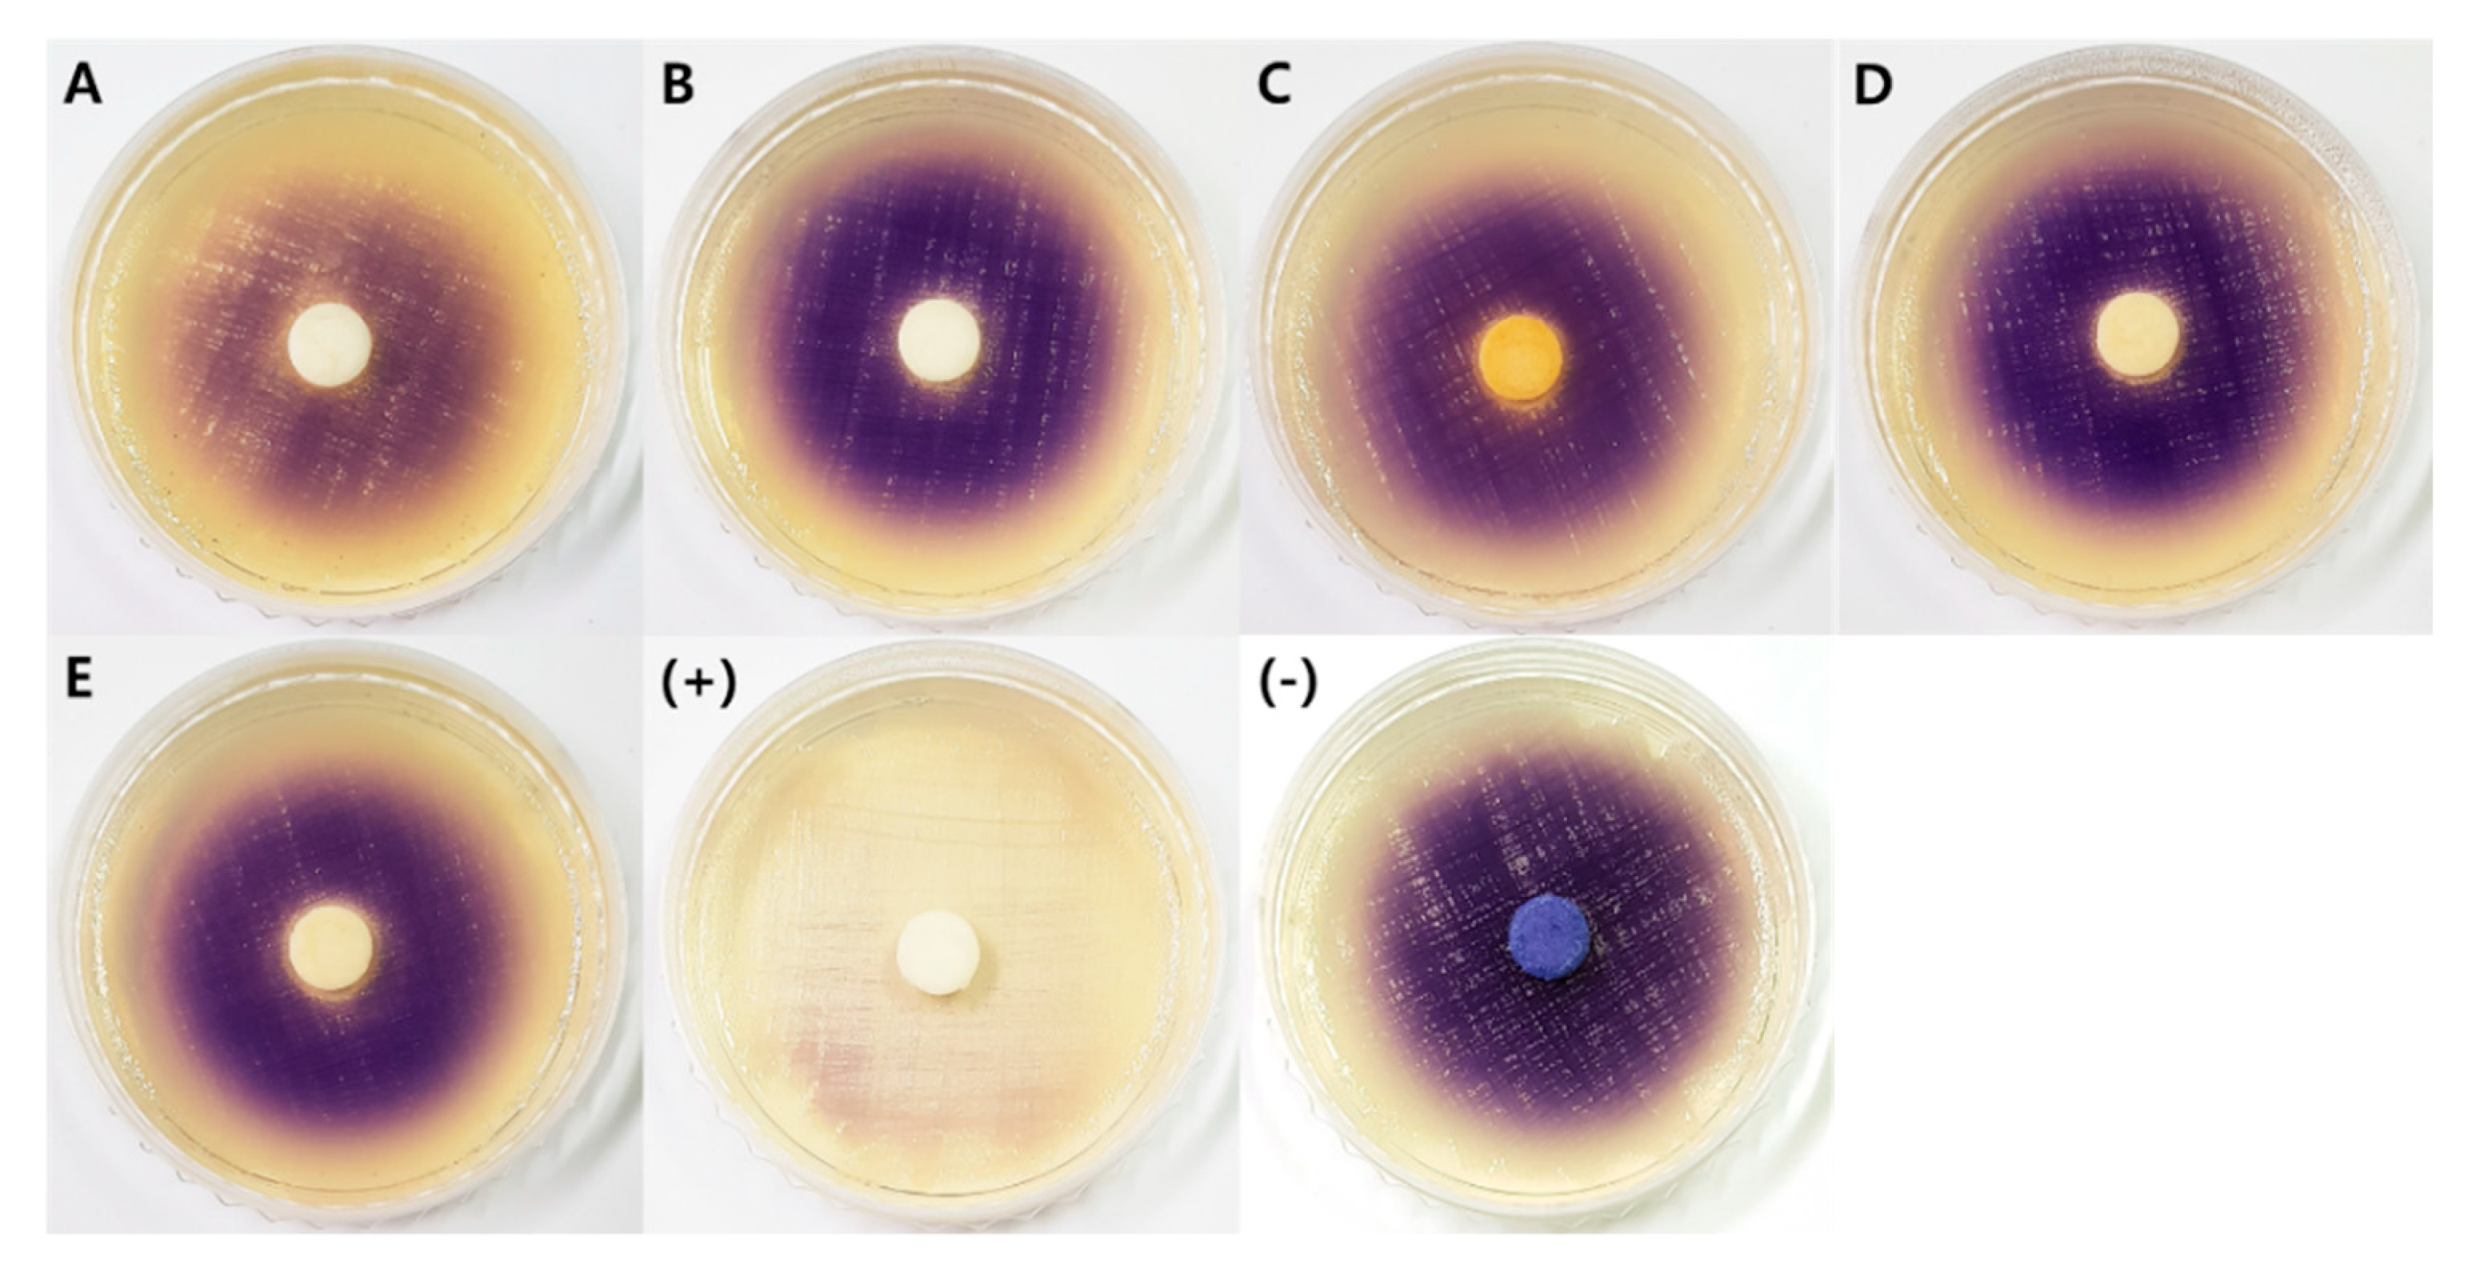
Marinedrugs 17 00601 g006

Fungal Diversity in Intertidal Mudflats and Abandoned Solar Salterns as a Source for Biological Resources
Abstract
1. Introduction
2. Results and Discussion
2.1. The Fungal Community in Intertidal Mudflats and Abandoned Salterns
2.1.1. Fungal Diversity and Recovery Assessment
2.1.2. Determination of Indicator Taxa
2.1.3. Diversity of Culturable Fungi
2.2. Biological Activities of Fungi from Intertidal Mudflats and Abandoned Salterns
2.2.1. Antioxidant Activity
2.2.2. Tyrosinase Inhibitory Activity
2.2.3. Antifungal Activity
2.2.4. Quorum Sensing Inhibitory Activity
3. Materials and Methods
3.1. Microorganisms and Diversity Analyses
3.1.1. Sediment Sampling and Fungal Isolation
3.1.2. DNA Extraction, PCR, and Identification
3.1.3. Phylogenetic Analysis
3.1.4. DNA library Preparation and Amplicon Sequencing
3.1.5. Bioinformatics Analyses
3.2. Preparation of Fungal Extracts
3.3. Biological Assays
3.3.1. Antioxidant Assay
ABTS Radical-Scavenging Assay
DPPH Radical-Scavenging Assay
3.3.2. Tyrosinase Inhibition Assay
3.3.3. Antifungal Assay
3.3.4. Quorum Sensing Inhibition Assay
3.4. Statistical Analyses
4. Conclusions
Supplementary Materials
Author Contributions
Funding
Conflicts of Interest
References
- Zhao, D.L.; Wang, D.; Tian, X.Y.; Cao, F.; Li, Y.Q.; Zhang, C.S. Anti-phytopathogenic and cytotoxic activities of crude extracts and secondary metabolites of marine-derived fungi. Mar. Drugs 2018, 16, 36. [Google Scholar] [CrossRef] [PubMed]
- Sridhar, K. Marine filamentous fungi: Diversity, distribution and bioprospecting. In Developments in Fungal Biology and Applied Mycology; Springer: Singapore, 2017; pp. 59–73. [Google Scholar]
- Saravanakumar, K.; Yu, C.; Dou, K.; Wang, M.; Li, Y.; Chen, J. Biodiversity of Trichoderma community in the tidal flats and wetland of southeastern China. PLoS ONE 2016, 11, e0168020. [Google Scholar] [CrossRef] [PubMed]
- Park, C.K.; Oh, B.H.; Lee, D.W. Hydraulic characteristics of the non-power soil cleaning and keeping system by the large-scale model test at the dike gate. J. Korean Soc. Agric. Eng. 2014, 56, 67–75. [Google Scholar]
- Park, N. The Eco-Economical Evaluation of Tidal Flat Restoration in Suncheon Bay; Pukyong National University: Busan, Korea, 2018. [Google Scholar]
- Kim, H.S. On the value of coastal wetlands created from conservation and restoration of tidal flat ecosystem. Korean Soc. Civ. Eng. Mag. 2018, 66, 8–9. [Google Scholar]
- Chávez, R.; Fierro, F.; García-Rico, R.O.; Vaca, I. Filamentous fungi from extreme environments as a promising source of novel bioactive secondary metabolites. Front. Microbiol. 2015, 6, 903. [Google Scholar] [CrossRef]
- Hong, J.H.; Jang, S.; Heo, Y.M.; Min, M.; Lee, H.; Lee, Y.M.; Lee, H.; Kim, J.J. Investigation of marine-derived fungal diversity and their exploitable biological activities. Mar. Drugs 2015, 13, 4137–4155. [Google Scholar] [CrossRef]
- Antón, J.; Rosselló-Mora, R.; Rodríguez-Valera, F.; Amann, R. Extremely halophilic bacteria in crystallizer ponds from solar salterns. Appl. Environ. Microbiol. 2000, 66, 3052–3057. [Google Scholar] [CrossRef]
- Ballav, S.; Kerkar, S.; Thomas, S.; Augustine, N. Halophilic and halotolerant actinomycetes from a marine saltern of Goa, India producing anti-bacterial metabolites. J. Biosci. Bioeng. 2015, 119, 323–330. [Google Scholar] [CrossRef]
- Chen, Q.; Zhao, Q.; Li, J.; Jian, S.; Ren, H. Mangrove succession enriches the sediment microbial community in South China. Sci. Rep. 2016, 6, 27468. [Google Scholar] [CrossRef]
- Thatoi, H.; Behera, B.C.; Mishra, R.R.; Dutta, S.K. Biodiversity and biotechnological potential of microorganisms from mangrove ecosystems: A review. Ann. Microbiol. 2013, 63, 1–19. [Google Scholar] [CrossRef]
- Lee, S.; Park, M.S.; Lim, Y.W. Diversity of marine-derived Aspergillus from tidal mudflats and sea sand in Korea. Mycobiology 2016, 44, 237–247. [Google Scholar] [CrossRef] [PubMed]
- Sonjak, S.; Udovič, M.; Wraber, T.; Likar, M.; Regvar, M. Diversity of halophytes and identification of arbuscular mycorrhizal fungi colonising their roots in an abandoned and sustained part of Sečovlje salterns. Soil Biol. Biochem. 2009, 41, 1847–1856. [Google Scholar] [CrossRef]
- Lee, H.; Lee, D.W.; Kwon, S.L.; Heo, Y.M.; Jang, S.; Kwon, B.O.; Khim, J.S.; Kim, G.H.; Kim, J.J. Importance of functional diversity in assessing the recovery of the microbial community after the Hebei Spirit oil spill in Korea. Environ. Int. 2019, 128, 89–94. [Google Scholar] [CrossRef] [PubMed]
- Yun, K.; Khong, T.T.; Leutou, A.S.; Kim, G.D.; Hong, J.; Lee, C.H.; Son, B.W. Cristazine, a new cytotoxic dioxopiperazine alkaloid from the mudflat-sediment-derived fungus Chaetomium cristatum. Chem. Pharm. Bull. 2016, 64, 59–62. [Google Scholar] [CrossRef]
- Nenkep, V.; Yun, K.; Son, B.W. Oxysporizoline, an antibacterial polycyclic quinazoline alkaloid from the marine-mudflat-derived fungus Fusarium oxysporum. J. Antibiot. 2016, 69, 709–711. [Google Scholar] [CrossRef]
- Leutou, A.S.; Yun, K.; Son, B.W. Induced production of 6, 9-dibromoflavasperone, a new radical scavenging naphthopyranone in the marine-mudflat-derived fungus Aspergillus niger. Arch. Pharmacal Res. 2016, 39, 806–810. [Google Scholar] [CrossRef]
- Yun, K.; Kondempudi, C.M.; Leutou, A.S.; Son, B.W. New production of a monoterpene glycoside, 1-O-(α-D-mannopyranosyl) geraniol, by the marine-derived fungus Thielavia hyalocarpa. Bull. Korean Chem. Soc. 2015, 36, 2391–2393. [Google Scholar] [CrossRef]
- Leutou, A.S.; Yun, K.; Son, B.W. New production of antibacterial polycyclic quinazoline alkaloid, thielaviazoline, from anthranilic acid by the marine-mudflat-derived fungus Thielavia sp. Nat. Prod. Sci. 2016, 22, 216–219. [Google Scholar] [CrossRef]
- Yun, K.; Leutou, A.S.; Rho, J.R.; Son, B.W. Formoxazine, a new pyrrolooxazine, and two amines from the marine–mudflat-derived fungus Paecilomyces formosus. Bull. Korean Chem. Soc. 2016, 37, 103–104. [Google Scholar] [CrossRef]
- Bernhard, A.E.; Marshall, D.; Yiannos, L. Increased variability of microbial communities in restored salt marshes nearly 30 years after tidal flow restoration. Estuar. Coasts 2012, 35, 1049–1059. [Google Scholar] [CrossRef]
- Meng, Q.; Yang, W.; Men, M.; Bello, A.; Xu, X.; Xu, B.; Deng, L.; Jiang, X.; Sheng, S.; Wu, X. Microbial community succession and response to environmental variables during cow manure and corn straw composting. Front. Microbiol. 2019, 10, 529. [Google Scholar] [CrossRef] [PubMed]
- Cleary, M.; Oskay, F.; Doğmuş, H.T.; Lehtijärvi, A.; Woodward, S.; Vettraino, A.M. Cryptic Risks to Forest Biosecurity Associated with the Global Movement of Commercial Seed. Forests 2019, 10, 459. [Google Scholar] [CrossRef]
- Dang, P.; Yu, X.; Le, H.; Liu, J.; Shen, Z.; Zhao, Z. Effects of stand age and soil properties on soil bacterial and fungal community composition in Chinese pine plantations on the Loess Plateau. PLoS ONE 2017, 12, e0186501. [Google Scholar] [CrossRef] [PubMed]
- Wu, J.; Yu, M.; Xu, J.; Du, J.; Ji, F.; Dong, F.; Li, X.; Shi, J. Impact of transgenic wheat with wheat yellow mosaic virus resistance on microbial community diversity and enzyme activity in rhizosphere soil. PLoS ONE 2014, 9, e98394. [Google Scholar] [CrossRef] [PubMed]
- Warton, D.I.; Wright, S.T.; Wang, Y. Distance-based multivariate analyses confound location and dispersion effects. Methods Ecol. Evol. 2012, 3, 89–101. [Google Scholar] [CrossRef]
- Bücking, H.; Liepold, E.; Ambilwade, P. The role of the mycorrhizal symbiosis in nutrient uptake of plants and the regulatory mechanisms underlying these transport processes. In Plant Science; Dhal, N.K., Sahu, S.C., Eds.; Books on Demand: Norderstedt, Germany, 2012; Volume 4, pp. 107–138. [Google Scholar]
- Streit, W.R.; Schmitz, R.A. Metagenomics—The key to the uncultured microbes. Curr. Opin. Microbiol. 2004, 7, 492–498. [Google Scholar] [CrossRef] [PubMed]
- Huang, W.Y.; Cai, Y.Z.; Xing, J.; Corke, H.; Sun, M. A potential antioxidant resource: Endophytic fungi from medicinal plants. Econ. Bot. 2007, 61, 14–30. [Google Scholar] [CrossRef]
- Amens, B. Dietary carcinogens and anticarcinogens. Science 1983, 221, 53. [Google Scholar]
- Yen, G.C.; Chang, Y.C.; Sheu, F.; Chiang, H.C. Isolation and characterization of antioxidant compounds from Aspergillus candidus broth filtrate. J. Agric. Food Chem. 2001, 49, 1426–1431. [Google Scholar] [CrossRef]
- Elaasser, M.M.; Abdel-Aziz, M.M.; El-Kassas, R.A. Antioxidant, antimicrobial, antiviral and antitumor activities of pyranone derivative obtained from Aspergillus candidus. J. Microbiol. Biotechnol. Res. 2017, 1, 5–17. [Google Scholar]
- Kumar, C.G.; Mongolla, P.; Pombala, S.; Kamle, A.; Joseph, J. Physicochemical characterization and antioxidant activity of melanin from a novel strain of Aspergillus bridgeri ICTF-201. Lett. Appl. Microbiol. 2011, 53, 350–358. [Google Scholar] [CrossRef] [PubMed]
- Li, X.; Li, X.M.; Xu, G.M.; Li, C.S.; Wang, B.G. Antioxidant metabolites from marine alga-derived fungus Aspergillus wentii EN-48. Phytochem. Lett. 2014, 7, 120–123. [Google Scholar] [CrossRef]
- Ishikawa, Y.; Morimoto, K.; Iseki, S. Atrovenetin as a potent antioxidant compound from Penicillium species. J. Am. Oil Chem. Soc. 1991, 68, 666–668. [Google Scholar] [CrossRef]
- Narasimhachari, N.; Gopalkrishnan, K.; Haskins, R.; Vining, L. The production of the antibiotic atrovenetin by a strain of Penicillium herquei Bainier & Sartory. Can. J. Microbiol. 1963, 9, 134–136. [Google Scholar]
- Neill, K.; Raistrick, H. Studies in the biochemistry of micro-organisms, doi:100. Metabolites of Penicillium atrovenetum G. Smith. Part I. Atrovenetin, a new crystalline colouring matter. Biochem. J. 1957, 65, 166. [Google Scholar] [CrossRef]
- Chen, C.H.; Shaw, C.Y.; Chen, C.C.; Tsai, Y.C. 2, 3, 4-trimethyl-5, 7-dihydroxy-2, 3-dihydrobenzofuran, a novel antioxidant, from Penicillium citrinum F5. J. Nat. Prod. 2002, 65, 740–741. [Google Scholar] [CrossRef]
- Hayashi, K.I.; Suzuki, K.; Kawaguchi, M.; Nakajima, T.; Suzuki, T.; Numata, M.; Nakamura, T. Isolation of an antioxidant from Penicillium roquefortii IFO 5956. Biosci. Biotechnol. Biochem. 1995, 59, 319–320. [Google Scholar] [CrossRef]
- Jakovljević, V.D.; Milićević, J.M.; Stojanović, J.D.; Solujić, S.R.; Vrvić, M.M. Antioxidant activity of ethanolic extract of Penicillium chrysogenum and Penicillium fumiculosum. Hem. Ind. 2014, 68, 43–49. [Google Scholar] [CrossRef]
- Bringmann, G.; Lang, G.; Gulder, T.A.; Tsuruta, H.; Mühlbacher, J.; Maksimenka, K.; Steffens, S.; Schaumann, K.; Stöhr, R.; Wiese, J.; et al. The first sorbicillinoid alkaloids, the antileukemic sorbicillactones A and B, from a sponge-derived Penicillium chrysogenum strain. Tetrahedron 2005, 61, 7252–7265. [Google Scholar] [CrossRef]
- Nenkep, V.N.; Yun, K.; Li, Y.; Choi, H.D.; Kang, J.S.; Son, B.W. New production of haloquinones, bromochlorogentisylquinones A and B, by a halide salt from a marine isolate of the fungus Phoma herbarum. J. Antibiot. 2010, 63, 199–201. [Google Scholar] [CrossRef] [PubMed]
- Li, H.L.; Li, X.M.; Li, X.; Wang, C.Y.; Liu, H.; Kassack, M.U.; Meng, L.H.; Wang, B.G. Antioxidant hydroanthraquinones from the marine algal-derived endophytic fungus Talaromyces islandicus EN-501. J. Nat. Prod. 2017, 80, 162–168. [Google Scholar] [CrossRef]
- Pandit, S.G.; Puttananjaih, M.H.; Harohally, N.V.; Dhale, M.A. Functional attributes of a new molecule-2-hydroxymethyl-benzoic acid 2′-hydroxy-tetradecyl ester isolated from Talaromyces purpureogenus CFRM02. Food Chem. 2018, 255, 89–96. [Google Scholar] [CrossRef] [PubMed]
- Guo, J.; Ran, H.; Zeng, J.; Liu, D.; Xin, Z. Tafuketide, a phylogeny-guided discovery of a new polyketide from Talaromyces funiculosus Salicorn 58. Appl. Microbiol. Biotechnol. 2016, 100, 5323–5338. [Google Scholar] [CrossRef] [PubMed]
- Yuan, W.H.; Teng, M.T.; Sun, S.S.; Ma, L.; Yuan, B.; Ren, Q.; Zhang, P. Active Metabolites from Endolichenic Fungus Talaromyces sp. Chem. Biodivers. 2018, 15, e1800371. [Google Scholar] [CrossRef] [PubMed]
- Chang, T.S. An updated review of tyrosinase inhibitors. Int. J. Mol. Sci. 2009, 10, 2440–2475. [Google Scholar] [CrossRef] [PubMed]
- Balboa, E.M.; Conde, E.; Soto, M.L.; Pérez-Armada, L.; Domínguez, H. Cosmetics from marine sources. In Springer Handbook of Marine Biotechnology; Springer: Berlin/Heidelberg, Germany, 2015; pp. 1015–1042. [Google Scholar]
- Tsuchiya, T.; Yamada, K.; Minoura, K.; Miyamoto, K.; Usami, Y.; Kobayashi, T.; Hamada-Sato, N.; Imada, C.; Tsujibo, H. Purification and determination of the chemical structure of the tyrosinase inhibitor produced by Trichoderma viride strain H1-7 from a marine environment. Biol. Pharm. Bull. 2008, 31, 1618–1620. [Google Scholar] [CrossRef]
- Lee, C.H.; Koshino, H.; Chung, M.C.; Lee, H.J.; Kho, Y.H. MR304A, a new melanin synthesis inhibitor produced by Trichoderma harzianum. J. Antibiot. 1995, 48, 1168–1170. [Google Scholar] [CrossRef][Green Version]
- Lee, C.H.; Koshino, H.; Chung, M.C.; Lee, H.J.; HONG, J.K.; Yoon, J.S.; Kho, Y.H. MR566A and MR566B, new melanin synthesis inhibitors produced by Trichoderma harzianum. J. Antibiot. 1997, 50, 474–478. [Google Scholar] [CrossRef][Green Version]
- Raghukumar, S. Fungi in Coastal and Oceanic Marine Ecosystems; Springer: New York, NY, USA, 2017. [Google Scholar]
- Skriptsova, A.V. Fucoidans of brown algae: Biosynthesis, localization, and physiological role in thallus. Russ. J. Mar. Biol. 2015, 41, 145–156. [Google Scholar] [CrossRef]
- Lane, A.L.; Mular, L.; Drenkard, E.J.; Shearer, T.L.; Engel, S.; Fredericq, S.; Fairchild, C.R.; Prudhomme, J.; Le Roch, K.; Hay, M.E.; et al. Ecological leads for natural product discovery: Novel sesquiterpene hydroquinones from the red macroalga Peyssonnelia sp. Tetrahedron 2010, 66, 455–461. [Google Scholar] [CrossRef]
- Bladt, T.; Frisvad, J.; Knudsen, P.; Larsen, T. Anticancer and antifungal compounds from Aspergillus, Penicillium and other filamentous fungi. Molecules 2013, 18, 11338–11376. [Google Scholar] [CrossRef] [PubMed]
- Gao, S.S.; Li, X.M.; Li, C.S.; Proksch, P.; Wang, B.G. Penicisteroids A and B, antifungal and cytotoxic polyoxygenated steroids from the marine alga-derived endophytic fungus Penicillium chrysogenum QEN-24S. Bioorg. Med. Chem. Lett. 2011, 21, 2894–2897. [Google Scholar] [CrossRef] [PubMed]
- Jackson, M.; Karwowski, J.P.; Humphrey, P.E.; Kohl, W.L.; Barlow, G.J.; Tanaka, S.K. Calbistrins, novel antifungal agents produced by Penicillium restrictum. J. Antibiot. 1993, 46, 34–38. [Google Scholar] [CrossRef] [PubMed]
- McCorkindale, N.J.; Wright, J.L.C.; Brian, P.W.; Clarke, S.M.; Hutchinson, S.A. Canadensolide—An antifungal metabolite of Penicillium canadense. Tetrahedron Lett. 1968, 9, 727–730. [Google Scholar] [CrossRef]
- Breinholt, J.; Jensen, G.W.; Nielsen, R.I.; Olsen, C.E.; Frisvad, J.C. Antifungal macrocyclic polylactones from Penicillium verruculosum. J. Antibiot. 1993, 46, 1101–1108. [Google Scholar] [CrossRef] [PubMed]
- Yamaji, K.; Fukushi, Y.; Hashidoko, Y.; Yoshida, T.; Tahara, S. Characterization of antifungal metabolites produced by Penicillium species isolated from seeds of Picea glehnii. J. Chem. Ecol. 1999, 25, 1643–1653. [Google Scholar] [CrossRef]
- Brown, A.G.; Smale, T.C.; King, T.J.; Hasenkamp, R.; Thompson, R.H. Crystal and molecular structure of compactin, a new antifungal metabolite from Penicillium brevicompactum. J. Chem. Soc. Perkin Trans. 1976, 11, 1165–1170. [Google Scholar] [CrossRef]
- Suzuki, S.; Hosoe, T.; Nozawa, K.; Kawai, K.I.; Yaguchi, T.; Udagawa, S.I. Antifungal substances against pathogenic fungi, talaroconvolutins, from Talaromyces convolutus. J. Nat. Prod. 2000, 63, 768–772. [Google Scholar] [CrossRef]
- Kim, K.K.A.; Fravel, D.R.; Papavizas, G. Glucose oxidase as the antifungal principle of talaron from Talaromyces flavus. Can. J. Microbiol. 1990, 36, 760–764. [Google Scholar] [CrossRef]
- Skandamis, P.N.; Nychas, G.J.E. Quorum sensing in the context of food microbiology. Appl. Environ. Microbiol. 2012, 78, 5473–5482. [Google Scholar] [CrossRef]
- Schultz, M.P.; Bendick, J.A.; Holm, E.R.; Hertel, W.M. Economic impact of biofouling on a naval surface ship. Biofouling 2011, 27, 87–98. [Google Scholar] [CrossRef] [PubMed]
- Olson, M.E.; Ceri, H.; Morck, D.W.; Buret, A.G.; Read, R.R. Biofilm bacteria: Formation and comparative susceptibility to antibiotics. Can. J. Vet. Res. 2002, 66, 86–92. [Google Scholar] [PubMed]
- Rasmussen, T.B.; Skindersoe, M.E.; Bjarnsholt, T.; Phipps, R.K.; Christensen, K.B.; Jensen, P.O.; Andersen, J.B.; Koch, B.; Larsen, T.O.; Hentzer, M. Identity and effects of quorum-sensing inhibitors produced by Penicillium species. Microbiology 2005, 151, 1325–1340. [Google Scholar] [CrossRef] [PubMed]
- Rajesh, P.; Rai, V.R. Hydrolytic enzymes and quorum sensing inhibitors from endophytic fungi of Ventilago madraspatana Gaertn. Biocatal. Agric. Biotechnol. 2013, 2, 120–124. [Google Scholar] [CrossRef]
- Zhu, H.; Liu, W.; Wang, S.X.; Tian, B.Z.; Zhang, S.S. Evaluation of anti-quorum-sensing activity of fermentation metabolites from different strains of a medicinal mushroom, Phellinus igniarius. Chemotherapy 2012, 58, 195–199. [Google Scholar] [CrossRef] [PubMed]
- Zhu, H.; He, C.C.; Chu, Q.H. Inhibition of quorum sensing in Chromobacterium violaceum by pigments extracted from Auricularia auricular. Lett. Appl. Microbiol. 2011, 52, 269–274. [Google Scholar] [CrossRef]
- Zhu, H.; Sun, S. Inhibition of bacterial quorum sensing-regulated behaviors by Tremella fuciformis extract. Curr. Microbiol. 2008, 57, 418–422. [Google Scholar] [CrossRef]
- Zhu, H.; Liu, W.; Tian, B.; Liu, H.; Ning, S. Inhibition of quorum sensing in the opportunistic pathogenic bacterium Chromobacterium violaceum by an extract from fruiting bodies of lingzhi or reishi medicinal mushroom, Ganoderma lucidum (w. Curt.: Fr.) p. Karst. (higher basidiomycetes). Int. J. Med. Mushrooms 2011, 13, 559–564. [Google Scholar] [CrossRef]
- Sharma, R.; Jangid, K. Fungal quorum sensing inhibitors. In Quorum Sensing Vs Quorum Quenching: A Battle with no End in Sight; Springer: New Delhi, India, 2015; pp. 237–257. [Google Scholar]
- Figueroa, M.; Jarmusch, A.K.; Raja, H.A.; El-Elimat, T.; Kavanaugh, J.S.; Horswill, A.R.; Cooks, R.G.; Cech, N.B.; Oberlies, N.H. Polyhydroxyanthraquinones as quorum sensing inhibitors from the guttates of Penicillium restrictum and their analysis by desorption electrospray ionization mass spectrometry. J. Nat. Prod. 2014, 77, 1351–1358. [Google Scholar] [CrossRef]
- Wang, M.; Hashimoto, M.; Hashidoko, Y. Repression of tropolone production and induction of a Burkholderia plantarii pseudo-biofilm by carot-4-en-9, 10-diol, a cell-to-cell signaling disrupter produced by Trichoderma virens. PLoS ONE 2013, 8, e78024. [Google Scholar] [CrossRef]
- Wang, L.; Zou, S.; Yin, S.; Liu, H.; Yu, W.; Gong, Q. Construction of an effective screening system for detection of Pseudomonas aeruginosa quorum sensing inhibitors and its application in bioautographic thin-layer chromatography. Biotechnol. Lett. 2011, 33, 1381–1387. [Google Scholar] [CrossRef] [PubMed]
- Stewart, M.; Capon, R.J.; White, J.M.; Lacey, E.; Tennant, S.; Gill, J.H.; Shaddock, M.P. Rugulotrosins A and B: Two new antibacterial metabolites from an Australian isolate of a Penicillium sp. J. Nat. Prod. 2004, 67, 728–730. [Google Scholar] [CrossRef] [PubMed]
- Bao, J.; Sun, Y.L.; Zhang, X.Y.; Han, Z.; Gao, H.C.; He, F.; Qian, P.Y.; Qi, S.H. Antifouling and antibacterial polyketides from marine gorgonian coral-associated fungus Penicillium sp. SCSGAF 0023. J. Antibiot. 2013, 66, 219–223. [Google Scholar] [CrossRef] [PubMed]
- Subramani, R.; Kumar, R.; Prasad, P.; Aalbersberg, W. Cytotoxic and antibacterial substances against multi-drug resistant pathogens from marine sponge symbiont: Citrinin, a secondary metabolite of Penicillium sp. Asian Pac. J. Trop. Biomed. 2013, 3, 291–296. [Google Scholar] [CrossRef]
- Zheng, C.J.; Yu, H.E.; Kim, E.H.; Kim, W.G. Viridicatumtoxin B, a new anti-MRSA agent from Penicillium sp. FR11. J. Antibiot. 2008, 61, 633–637. [Google Scholar] [CrossRef]
- Jouda, J.B.; Kusari, S.; Lamshöft, M.; Talontsi, F.M.; Meli, C.D.; Wandji, J.; Spiteller, M. Penialidins A–C with strong antibacterial activities from Penicillium sp. an endophytic fungus harboring leaves of Garcinia nobilis. Fitoterapia 2014, 98, 209–214. [Google Scholar] [CrossRef]
- Guo, W.; Zhang, Z.; Zhu, T.; Gu, Q.; Li, D. Penicyclones A–E, antibacterial polyketides from the deep-sea-derived fungus Penicillium sp. F23-2. J. Nat. Prod. 2015, 78, 2699–2703. [Google Scholar] [CrossRef]
- Fleming, A. On the antibacterial action of cultures of a penicillium, with special reference to their use in the isolation of B. influenzae. Br. J. Exp. Pathol. 1929, 10, 226–236. [Google Scholar] [CrossRef]
- Broadbent, D.; Mabelis, R.P.; Spencer, H. 3,6,8-Trihydroxy-1-methylxanthone—An antibacterial metabolite from Penicillium patulum. Phytochemistry 1975, 14, 2082–2083. [Google Scholar] [CrossRef]
- Devi, P.; Rodrigues, C.; Naik, C.; D’Souza, L. Isolation and characterization of antibacterial compound from a mangrove-endophytic fungus, Penicillium chrysogenum MTCC 5108. Indian J. Microbiol. 2012, 52, 617–623. [Google Scholar] [CrossRef]
- Brian, P.; Curtis, P.; Grove, J.; Hemming, H.; McGowan, J. Gladiolic acid: An antifungal and antibacterial metabolic product of Penicillium gladioli McCull and Thom. Nature 1946, 157, 697. [Google Scholar] [CrossRef]
- Suzuki, K.; Nozawa, K.; Nakajima, S.; Udagawa, S.I.; Kawai, K.I. Isolation and structures of antibacterial binaphtho-α-pyrones, talaroderxines A and B, from Talaromyces derxii. Chem. Pharm. Bull. 1992, 40, 1116–1119. [Google Scholar] [CrossRef] [PubMed][Green Version]
- Zhao, Q.H.; Yang, Z.D.; Shu, Z.M.; Wang, Y.G.; Wang, M.G. Secondary metabolites and biological activities of Talaromyces sp. LGT-2, an endophytic fungus from Tripterygium wilfordii. Iran. J. Pharm. Res. 2016, 15, 453–457. [Google Scholar] [PubMed]
- Houbraken, J.; Samson, R.A. Phylogeny of Penicillium and the segregation of Trichocomaceae into three families. Stud. Mycol. 2011, 70, 1–51. [Google Scholar] [CrossRef] [PubMed]
- Jin, P.; Zuo, W.; Guo, Z.; Mei, W.; Dai, H. Metabolites from the endophytic fungus Penicillium sp. FJ-1 of Ceriops tagal. Acta Pharm. Sin. 2013, 48, 1688–1691. [Google Scholar]
- Liu, F.; Cai, X.L.; Yang, H.; Xia, X.K.; Guo, Z.Y.; Yuan, J.; Li, M.F.; She, Z.G.; Lin, Y.C. The bioactive metabolites of the mangrove endophytic fungus Talaromyces sp. ZH-154 isolated from Kandelia candel (L.) Druce. Planta Med. 2010, 76, 185–189. [Google Scholar] [CrossRef] [PubMed]
- Wu, B.; Ohlendorf, B.; Oesker, V.; Wiese, J.; Malien, S.; Schmaljohann, R.; Imhoff, J.F. Acetylcholinesterase inhibitors from a marine fungus Talaromyces sp. strain LF458. Mar. Biotechnol. 2015, 17, 110–119. [Google Scholar] [CrossRef]
- Stark, A.A.; Townsend, J.M.; Wogan, G.N.; Demain, A.L.; Manmade, A.; Ghosh, A.C. Mutagenicity and antibacterial activity of mycotoxins produced by Penicillium islandicum Sopp and Penicillium rugulosum. J. Environ. Pathol. Toxicol. 1978, 2, 313–324. [Google Scholar]
- Brian, P.; Curtis, P.; Hemming, H.; Norris, G. Wortmannin, an antibiotic produced by Penicillium wortmanni. Trans. Br. Mycol. Soc. 1957, 40, 365–368. [Google Scholar] [CrossRef]
- Bara, R.; Zerfass, I.; Aly, A.H.; Goldbach-Gecke, H.; Raghavan, V.; Sass, P.; Mandi, A.; Wray, V.; Polavarapu, P.L.; Pretsch, A. Atropisomeric dihydroanthracenones as inhibitors of multiresistant Staphylococcus aureus. J. Med. Chem. 2013, 56, 3257–3272. [Google Scholar] [CrossRef]
- Miao, F.; Yang, R.; Chen, D.D.; Wang, Y.; Qin, B.F.; Yang, X.J.; Zhou, L. Isolation, identification and antimicrobial activities of two secondary metabolites of Talaromyces verruculosus. Molecules 2012, 17, 14091–14098. [Google Scholar] [CrossRef] [PubMed]
- Chen, S.; Liu, Y.; Liu, Z.; Cai, R.; Lu, Y.; Huang, X.; She, Z. Isocoumarins and benzofurans from the mangrove endophytic fungus Talaromyces amestolkiae possess α-glucosidase inhibitory and antibacterial activities. RSC Adv. 2016, 6, 26412–26420. [Google Scholar] [CrossRef]
- Yamazaki, M.; Okuyama, E. Isolation and structures of oxaphenalenone dimers from Talaromyces bacillosporus. Chem. Pharm. Bull. 1980, 28, 3649–3655. [Google Scholar] [CrossRef]
- Zhai, M.M.; Niu, H.T.; Li, J.; Xiao, H.; Shi, Y.P.; Di, D.L.; Crews, P.; Wu, Q.X. Talaromycolides A–C, novel phenyl-substituted phthalides isolated from the green Chinese onion-derived fungus Talaromyces pinophilus AF-02. J. Agric. Food Chem. 2015, 63, 9558–9564. [Google Scholar] [CrossRef]
- Ren, J.; Ding, S.S.; Zhu, A.; Cao, F.; Zhu, H.J. Bioactive azaphilone derivatives from the fungus Talaromyces aculeatus. J. Nat. Prod. 2017, 80, 2199–2203. [Google Scholar] [CrossRef]
- Huang, H.; Liu, T.; Wu, X.; Guo, J.; Lan, X.; Zhu, Q.; Zheng, X.; Zhang, K. A new antibacterial chromone derivative from mangrove-derived fungus Penicillium aculeatum (No. 9EB). Nat. Prod. Res. 2017, 31, 2593–2598. [Google Scholar] [CrossRef]
- Li, H.L.; Li, X.M.; Liu, H.; Meng, L.H.; Wang, B.G. Two new diphenylketones and a new xanthone from Talaromyces islandicus EN-501, an endophytic fungus derived from the marine red alga Laurencia okamurai. Mar. Drugs 2016, 14, 223. [Google Scholar] [CrossRef]
- Cai, R.; Chen, S.; Long, Y.; Li, C.; Huang, X.; She, Z. Depsidones from Talaromyces stipitatus SK-4, an endophytic fungus of the mangrove plant Acanthus ilicifolius. Phytochem. Lett. 2017, 20, 196–199. [Google Scholar] [CrossRef]
- Li, G.H.; Zheng, L.J.; Liu, F.F.; Dang, L.Z.; Li, L.; Huang, R.; Zhang, K.Q. New cyclopentenones from strain Trichoderma sp. YLF-3. Nat. Prod. Res. 2009, 23, 1431–1435. [Google Scholar] [CrossRef]
- Adachi, T.; Aoki, H.; Osawa, T.; Namiki, M.; Yamane, T.; Ashida, T. Structure of trichodermaol, antibacterial substance produced in combined culture of Trichoderma sp. with Fusarium oxysporum or Fusarium solani. Chem. Lett. 1983, 12, 923–926. [Google Scholar] [CrossRef]
- Zhang, J.C.; Chen, G.Y.; Li, X.Z.; Hu, M.; Wang, B.Y.; Ruan, B.H.; Zhou, H.; Zhao, L.X.; Zhou, J.; Ding, Z.T. Phytotoxic, antibacterial, and antioxidant activities of mycotoxins and other metabolites from Trichoderma sp. Nat. Prod. Res. 2017, 31, 2745–2752. [Google Scholar] [CrossRef] [PubMed]
- Rebuffat, S.; Goulard, C.; Hlimi, S.; Bodo, B. Two unprecedented natural Aib-peptides with the (Xaa-Yaa-Aib-Pro) motif and an unusual C-terminus: Structures, membrane-modifying and antibacterial properties of pseudokonins KL III and KL VI from the fungus Trichoderma pseudokoningii. J. Pept. Sci. 2000, 6, 519–533. [Google Scholar] [CrossRef]
- Ooka, T.; Shimojima, Y.; Akimoto, T.; Takeda, I.; Senoh, S.; Abe, J. A new antibacterial peptide “suzukacillin”. Agric. Biol. Chem. 1966, 30, 700–702. [Google Scholar] [CrossRef]
- Brian, P.; Curtis, P.; Hemming, H.; McGowan, J. The production of viridin by pigment-forming strains of Trichoderma viride. Ann. Appl. Biol. 1946, 33, 190–200. [Google Scholar] [CrossRef] [PubMed]
- Berg, A.; Kemami Wangun, H.V.; Nkengfack, A.E.; Schlegel, B. Lignoren, a new sesquiterpenoid metabolite from Trichoderma lignorum HKI 0257. J. Basic Microbiol. 2004, 44, 317–319. [Google Scholar] [CrossRef] [PubMed]
- Reino, J.L.; Guerrero, R.F.; Hernández-Galán, R.; Collado, I.G. Secondary metabolites from species of the biocontrol agent Trichoderma. Phytochem. Rev. 2008, 7, 89–123. [Google Scholar] [CrossRef]
- Tarus, P.K.; Lang’at-Thoruwa, C.C.; Wanyonyi, A.W.; Chhabra, S.C. Bioactive metabolites from Trichoderma harzianum and Trichoderma longibrachiatum. Bull. Chem. Soc. Ethiop. 2003, 17, 185–190. [Google Scholar]
- Dang, L.; Li, G.; Yang, Z.; Luo, S.; Zheng, X.; Zhang, K. Chemical constituents from the endophytic fungus Trichoderma ovalisporum isolated from Panax notoginseng. Ann. Microbiol. 2010, 60, 317–320. [Google Scholar] [CrossRef]
- Khamthong, N.; Rukachaisirikul, V.; Tadpetch, K.; Kaewpet, M.; Phongpaichit, S.; Preedanon, S.; Sakayaroj, J. Tetrahydroanthraquinone and xanthone derivatives from the marine-derived fungus Trichoderma aureoviride PSU-F95. Arch. Pharmacal Res. 2012, 35, 461–468. [Google Scholar] [CrossRef]
- Gardes, M.; Bruns, T.D. ITS primers with enhanced specificity for basidiomycetes-application to the identification of mycorrhizae and rusts. Mol. Ecol. 1993, 2, 113–118. [Google Scholar] [CrossRef]
- Bellemain, E.; Carlsen, T.; Brochmann, C.; Coissac, E.; Taberlet, P.; Kauserud, H. ITS as an environmental DNA barcode for fungi: An in silico approach reveals potential PCR biases. BMC Microbiol. 2010, 10, 189. [Google Scholar] [CrossRef] [PubMed]
- Glass, N.L.; Donaldson, G.C. Development of primer sets designed for use with the PCR to amplify conserved genes from filamentous ascomycetes. Appl. Environ. Microbiol. 1995, 61, 1323–1330. [Google Scholar] [PubMed]
- O’Donnell, K.; Kistler, H.C.; Cigelnik, E.; Ploetz, R.C. Multiple evolutionary origins of the fungus causing Panama disease of banana: Concordant evidence from nuclear and mitochondrial gene genealogies. Proc. Natl. Acad. Sci. USA 1998, 95, 2044–2049. [Google Scholar] [CrossRef] [PubMed]
- Kumar, S.; Stecher, G.; Tamura, K. MEGA7: Molecular evolutionary genetics analysis version 7.0 for bigger datasets. Mol. Biol. Evol. 2016, 33, 1870–1874. [Google Scholar] [CrossRef]
- Katoh, K.; Standley, D.M. MAFFT multiple sequence alignment software version 7: Improvements in performance and usability. Mol. Biol. Evol. 2013, 30, 772–780. [Google Scholar] [CrossRef]
- Maddison, D.R.; Maddison, W.P. MacClade 4: Analysis of Phylogeny and Character Evolution; Version 4.08 a. Sinauer Associates: Sunderland, MA, USA, 2005. [Google Scholar]
- Nylander, J.A.A. MrModeltest v2. Program distributed by the author; Evolutionary Biology Center, Uppsala University: Uppsala, Sweden, 2004. [Google Scholar]
- Ronquist, F.; Huelsenbeck, J.P. MrBayes 3: Bayesian phylogenetic inference under mixed models. Bioinformatics 2003, 19, 1572–1574. [Google Scholar] [CrossRef]
- Ihrmark, K.; Bödeker, I.; Cruz-Martinez, K.; Friberg, H.; Kubartova, A.; Schenck, J.; Strid, Y.; Stenlid, J.; Brandström-Durling, M.; Clemmensen, K.E.; et al. New primers to amplify the fungal ITS2 region—Evaluation by 454-sequencing of artificial and natural communities. FEMS Microbiol. Ecol. 2012, 82, 666–677. [Google Scholar] [CrossRef]
- Caporaso, J.G.; Kuczynski, J.; Stombaugh, J.; Bittinger, K.; Bushman, F.D.; Costello, E.K.; Fierer, N.; Pena, A.G.; Goodrich, J.K.; Gordon, J.I.; et al. QIIME allows analysis of high-throughput community sequencing data. Nat. Methods 2010, 7, 335–336. [Google Scholar] [CrossRef]
- Rognes, T.; Flouri, T.; Nichols, B.; Quince, C.; Mahé, F. VSEARCH: A versatile open source tool for metagenomics. PeerJ 2016, 4, e2584. [Google Scholar] [CrossRef]
- Nilsson, R.H.; Tedersoo, L.; Ryberg, M.; Kristiansson, E.; Hartmann, M.; Unterseher, M.; Porter, T.M.; Bengtsson-Palme, J.; Walker, D.M.; de Sousa, F.; et al. A comprehensive, automatically updated fungal ITS sequence dataset for reference-based chimera control in environmental sequencing efforts. Microbes Environ. 2015, 30, 145–150. [Google Scholar] [CrossRef]
- Segata, N.; Izard, J.; Waldron, L.; Gevers, D.; Miropolsky, L.; Garrett, W.S.; Huttenhower, C. Metagenomic biomarker discovery and explanation. Genome Biol. 2011, 12, R60. [Google Scholar] [CrossRef] [PubMed]
- Dufrêne, M.; Legendre, P. Species assemblages and indicator species: The need for a flexible asymmetrical approach. Ecol. Monogr. 1997, 67, 345–366. [Google Scholar] [CrossRef]
- Wang, Y.; Naumann, U.; Wright, S.T.; Warton, D.I. Mvabund—An R package for model-based analysis of multivariate abundance data. Methods Ecol. Evol. 2012, 3, 471–474. [Google Scholar] [CrossRef]
- Heo, Y.M.; Kim, K.; Ryu, S.M.; Kwon, S.L.; Park, M.Y.; Kang, J.E.; Hong, J.H.; Lim, Y.W.; Kim, C.; Kim, B.S.; et al. Diversity and ecology of marine algicolous Arthrinium species as a source of bioactive natural products. Mar. Drugs 2018, 16, 508. [Google Scholar] [CrossRef]
- Lai, H.Y.; Lim, Y.Y.; Tan, S.P. Antioxidative, tyrosinase inhibiting and antibacterial activities of leaf extracts from medicinal ferns. Biosci. Biotechnol. Biochem. 2009, 73, 1362–1366. [Google Scholar] [CrossRef]
- Kim, J.D.; Han, J.W.; Hwang, I.C.; Lee, D.; Kim, B.S. Identification and biocontrol efficacy of Streptomyces miharaensis producing filipin III against Fusarium wilt. J. Basic Microbiol. 2012, 52, 150–159. [Google Scholar] [CrossRef]
- Kang, J.E.; Han, J.W.; Jeon, B.J.; Kim, B.S. Efficacies of quorum sensing inhibitors, piericidin A and glucopiericidin A, produced by Streptomyces xanthocidicus KPP01532 for the control of potato soft rot caused by Erwinia carotovora subsp. atroseptica. Microbiol. Res. 2016, 184, 32–41. [Google Scholar] [CrossRef]

| Sample | Shannon-Wiener Index (H’) | Gini-Simpson Index (DS, 1-λ) |
|---|---|---|
| Gopado | ||
| Abandoned saltern (RS) | 4.177 | 0.928 |
| Mudflat | 3.607 | 0.885 |
| Yubudo | ||
| Abandoned saltern (RS) | 4.433 | 0.954 |
| Mudflat | 3.901 | 0.806 |
| Yongyudo | ||
| Abandoned saltern (NS) | 1.471* | 0.477* |
| Mudflat | 3.497 | 0.859 |
| Taxa | Group | IndVal Score | p Value | Frequency |
|---|---|---|---|---|
| Ascomycota | ||||
| Stemphylium | NS | 1.0000 | 0.005 | 8 |
| Lecanoromycetes | NS | 0.9012 | 0.007 | 17 |
| Pertusariales | NS | 0.9266 | 0.005 | 16 |
| Basidiomycota | ||||
| Chionosphaeraceae | RS | 0.9137 | 0.005 | 15 |
| Ballistosporomyces sasicola | RS | 0.9137 | 0.006 | 13 |
| Tremellales | NS | 0.9238 | 0.005 | 12 |
| Tremellaceae | NS | 0.9362 | 0.004 | 12 |
| Tremella | NS | 0.9359 | 0.005 | 9 |
| Chytridiomycota | ||||
| Zygorhizidium planktonicum | RS | 0.9322 | 0.003 | 8 |
| Entorrhizomycota | NS | 0.9995 | 0.004 | 16 |
| Entorrhizomycetes | NS | 0.9995 | 0.003 | 16 |
| Mucoromycota | ||||
| Umbelopsidomycetes | Mudflat | 0.9553 | 0.001 | 5 |
| Umbelopsis sp. | Mudflat | 0.9632 | 0.001 | 5 |
| Taxa | Dev. | p Value |
|---|---|---|
| Ascomycota | ||
| Leptosporella | 26.15 | 0.035 |
| Basidiomycota | ||
| Agaricostilbomycetes | 23.23 | 0.011 |
| Chytridiomycota | 21.43 | 0.011 |
| Rhizophydiales | 33.15 | 0.008 |
| Rhizophydiaceae | 31.84 | 0.013 |
| Chytridiomycetes | 23.13 | 0.013 |
| Entorrhizomycota | 34.62 | 0.004 |
| Entorrhizomycetes | 34.62 | 0.003 |
| Entorrhizaceae | 30.59 | 0.015 |
| Entorrhiza cypericola | 27.29 | 0.001 |
| Glomeromycota | ||
| Gigasporales | 36.90 | 0.005 |
| Mucoromycota | ||
| Umbelopsidomycetes | 22.20 | 0.018 |
| Umbelopsidaceae | 23.36 | 0.047 |
| Rozellomycota | 16.23 | 0.033 |
| Fungal Name | KUC ID | Isolation Source | GenBank Accession Number | |||
|---|---|---|---|---|---|---|
| Location | Environmental Type | ITS | benA | EF1-α | ||
| Acremonium sp. | 21384 | Yongyudo | Abandoned saltern (NS) | MN518379 | N.D. | N.D. |
| Aspergillus urmiensis | 21379 | MN518380 | N.D. | N.D. | ||
| A. urmiensis | 21392 | MN518381 | N.D. | N.D. | ||
| A. urmiensis | 21396 | MN518382 | N.D. | N.D. | ||
| Cladosporium sphaerospermum | 21388 | MN518383 | N.D. | N.D. | ||
| Emericellopsis microspora | 21381 | MN518384 | N.D. | N.D. | ||
| Gibellulopsis nigrescens | 21385 | MN518385 | N.D. | N.D. | ||
| Humicola alopallonella | 21393 | MN518386 | N.D. | N.D. | ||
| Lulwoana sp. | 21398 | MN518387 | N.D. | N.D. | ||
| Nectriaceae sp. | 21383 | MN518388 | N.D. | N.D. | ||
| Neocamarosporium betae | 21428 | MN518389 | N.D. | N.D. | ||
| Penicillium chrysogenum | 21395 | MN518390 | N.D. | N.D. | ||
| Penicillium citrinum | 21390 | MN518391 | N.D. | N.D. | ||
| Penicillium sumatrense | 21382 | MN518392 | N.D. | N.D. | ||
| Penicillium sp. 1 | 21380 | MN518393 | N.D. | N.D. | ||
| Penicillium sp. 1 | 21386 | MN518394 | N.D. | N.D. | ||
| Penicillium sp. 1 | 21387 | MN518395 | N.D. | N.D. | ||
| Penicillium sp. 1 | 21389 | MN518396 | N.D. | N.D. | ||
| Penicillium sp. 1 | 21399 | MN518397 | N.D. | N.D. | ||
| Phanerochaete chrysosporium | 10791 | MN518398 | N.D. | N.D. | ||
| Simplicillium aogashimaense | 21397 | MN518399 | N.D. | N.D. | ||
| Sporormiaceae sp. | 21391 | MN518400 | N.D. | N.D. | ||
| Trichoderma harzianum | 21394 | MN518401 | N.D. | MN580170 | ||
| Acremonium persicinum | 21416 | Mudflat | MN518402 | N.D. | N.D. | |
| Amorphotheca resinae | 21414 | MN518403 | N.D. | N.D. | ||
| Aspergillus floccosus | 21405 | MN518404 | N.D. | N.D. | ||
| Helotiaceae sp. | 21409 | MN518405 | N.D. | N.D. | ||
| Penicillium sp. 2 | 21400 | MN518406 | N.D. | N.D. | ||
| Pseudogymnoascus pannorum | 21417 | MN518407 | N.D. | N.D. | ||
| Sporothrix mexicana | 21410 | MN518408 | N.D. | N.D. | ||
| Talaromyces liani | 21412 | MN518409 | MN531288 | N.D. | ||
| Talaromyces stipitatus | 21402 | MN518410 | MN531294 | N.D. | ||
| Talaromyces sp. 2 | 21413 | MN518411 | MN531292 | N.D. | ||
| Talaromyces sp. 3 | 21415 | MN518412 | MN531289 | N.D. | ||
| Talaromyces sp. 4 | 21408 | MN518413 | MN531293 | N.D. | ||
| Trichoderma koningiopsis | 21403 | MN518414 | N.D. | MN580171 | ||
| Trichoderma afroharzianum | 21401 | MN518415 | N.D. | MN580166 | ||
| T. afroharzianum | 21404 | MN518416 | N.D. | MN580167 | ||
| T. afroharzianum | 20406 | MN518417 | N.D. | MN580168 | ||
| Trichoderma harzianum | 21411 | MN518418 | N.D. | MN580169 | ||
| Westerdykella capitulum | 21407 | MN518419 | N.D. | N.D. | ||
| Cladosporium sp. | 21418 | Gopado | Abandoned saltern (RS) | MN518420 | N.D. | N.D. |
| Leptosphaeria sp. | 21419 | MN518421 | N.D. | N.D. | ||
| Hypocreales sp. | 21420 | Mudflat | MN518422 | N.D. | N.D. | |
| Talaromyces sp. 3 | 21421 | MN518423 | MN531290 | N.D. | ||
| Aspergillaceae sp. | 21424 | Yubudo | Abandoned saltern (RS) | MN518424 | N.D. | N.D. |
| Aspergillus japonicus | 21425 | MN518425 | N.D. | N.D. | ||
| Aspergillus tritici | 21427 | MN518426 | N.D. | N.D. | ||
| Paracamarosporium sp. | 21423 | MN518427 | N.D. | N.D. | ||
| Phoma sp. | 21426 | MN518428 | N.D. | N.D. | ||
| Pseudeurotium bakeri | 21422 | MN518429 | N.D. | N.D. | ||
| Talaromyces sp. 1 | 21276 | MN518430 | MN531291 | N.D. | ||
| Monascus sp. | 21277 | Mudflat | MN518431 | N.D. | N.D. | |
| FUNGAL NAME | KUC ID | Antioxidant Activity | Tyrosinase Inhibitory Activity | Antifungal Activity | ||
|---|---|---|---|---|---|---|
| ABTS | DPPH | Asteromyces cruciatus | Lindra thalassiae | |||
| (IC50, μg/mL) | (MIC, μg/mL) | |||||
| Acremonium persicinum | 21416 | > 50 | > 1000 | N.D. | N.D. | > 100 |
| Aspergillus floccosus | 21405 | 21.01 | 84.65 | N.D. | N.D. | 100 |
| Aspergillus japonicus | 21425 | 12.29 | 69.06 | N.D. | N.D. | > 100 |
| Aspergillus urmiensis | 21396 | 22.75 | 105.67 | N.D. | N.D. | N.D. |
| Cladosporium sphaerospermum | 21388 | > 50 | > 500 | 66.57 | N.D. | N.D. |
| Lulwoana sp. | 21398 | > 50 | > 1000 | > 417 | N.D. | N.D. |
| Paracamarosporium sp. | 21423 | > 50 | > 500 | N.D. | N.D. | > 100 |
| Penicillium chrysogenum | 21395 | 56.75 | 214.14 | N.D. | N.D. | N.D. |
| Penicillium citrinum | 21390 | > 50 | > 1000 | 96.06 | N.D. | N.D. |
| Penicillium sp. 1 | 21380 | > 50 | > 500 | N.D. | 50.00 | > 100 |
| Penicillium sp. 1 | 21386 | 10.24 | 102.53 | N.D. | 12.50 | > 100 |
| Penicillium sp. 1 | 21387 | 16.34 | 91.48 | N.D. | 50.00 | 100 |
| Penicillium sp. 1 | 21389 | 11.88 | 101.30 | N.D. | < 6.25 | 25 |
| Penicillium sumatrense | 21382 | > 50 | > 1000 | N.D. | N.D. | > 100 |
| Phoma sp. | 21426 | 6.31 | 40.41 | N.D. | N.D. | N.D. |
| Pseudeurotium bakeri | 21422 | > 50 | > 1000 | N.D. | < 6.25 | 100 |
| Talaromyces liani | 21412 | 27.58 | 208.09 | N.D. | > 100 | > 100 |
| Talaromyces sp. 1 | 21276 | > 50 | > 1000 | N.D. | N.D. | > 100 |
| Talaromyces sp. 3 | 21415 | > 50 | > 1000 | N.D. | > 100 | 50 |
| Talaromyces sp. 3 | 21421 | > 50 | > 1000 | N.D. | > 100 | 100 |
| Trichoderma harzianum | 21394 | > 50 | > 500 | N.D. | N.D. | > 100 |
| T. harzianum | 21411 | > 50 | > 500 | 121.00 | N.D. | > 100 |
| Westerdykella capitulum | 21407 | > 50 | N.D. | > 417 | N.D. | N.D. |
| Ascorbic acid * | 13.70 | 6.80 | ||||
| Kojic acid * | 49.32 | |||||
© 2019 by the authors. Licensee MDPI, Basel, Switzerland. This article is an open access article distributed under the terms and conditions of the Creative Commons Attribution (CC BY) license (http://creativecommons.org/licenses/by/4.0/).
Share and Cite
Heo, Y.M.; Lee, H.; Kim, K.; Kwon, S.L.; Park, M.Y.; Kang, J.E.; Kim, G.-H.; Kim, B.S.; Kim, J.-J. Fungal Diversity in Intertidal Mudflats and Abandoned Solar Salterns as a Source for Biological Resources. Mar. Drugs 2019, 17, 601. https://doi.org/10.3390/md17110601
Heo YM, Lee H, Kim K, Kwon SL, Park MY, Kang JE, Kim G-H, Kim BS, Kim J-J. Fungal Diversity in Intertidal Mudflats and Abandoned Solar Salterns as a Source for Biological Resources. Marine Drugs. 2019; 17(11):601. https://doi.org/10.3390/md17110601
Chicago/Turabian StyleHeo, Young Mok, Hanbyul Lee, Kyeongwon Kim, Sun Lul Kwon, Min Young Park, Ji Eun Kang, Gyu-Hyeok Kim, Beom Seok Kim, and Jae-Jin Kim. 2019. "Fungal Diversity in Intertidal Mudflats and Abandoned Solar Salterns as a Source for Biological Resources" Marine Drugs 17, no. 11: 601. https://doi.org/10.3390/md17110601
APA StyleHeo, Y. M., Lee, H., Kim, K., Kwon, S. L., Park, M. Y., Kang, J. E., Kim, G.-H., Kim, B. S., & Kim, J.-J. (2019). Fungal Diversity in Intertidal Mudflats and Abandoned Solar Salterns as a Source for Biological Resources. Marine Drugs, 17(11), 601. https://doi.org/10.3390/md17110601

